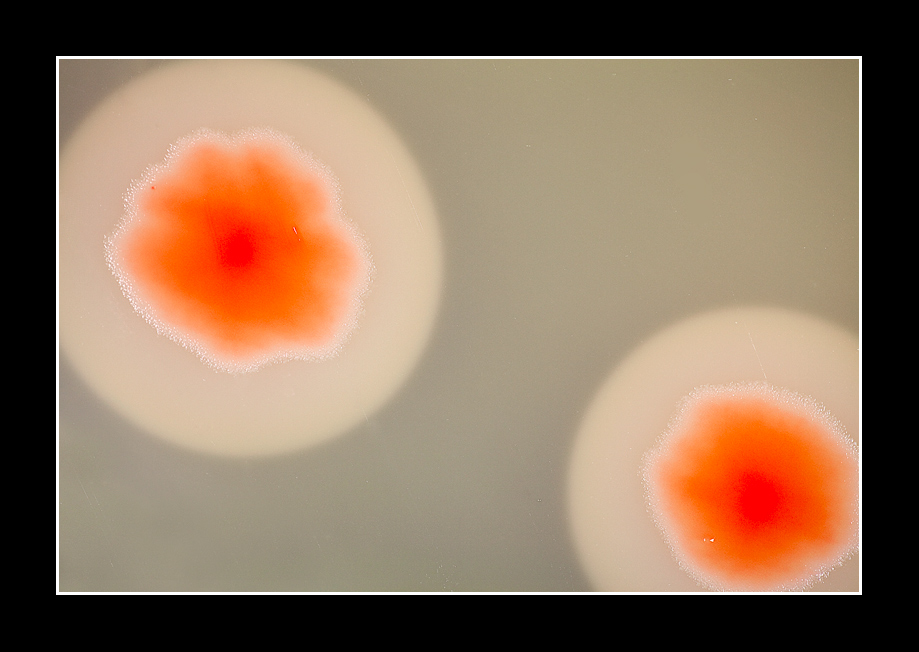
03.jpg
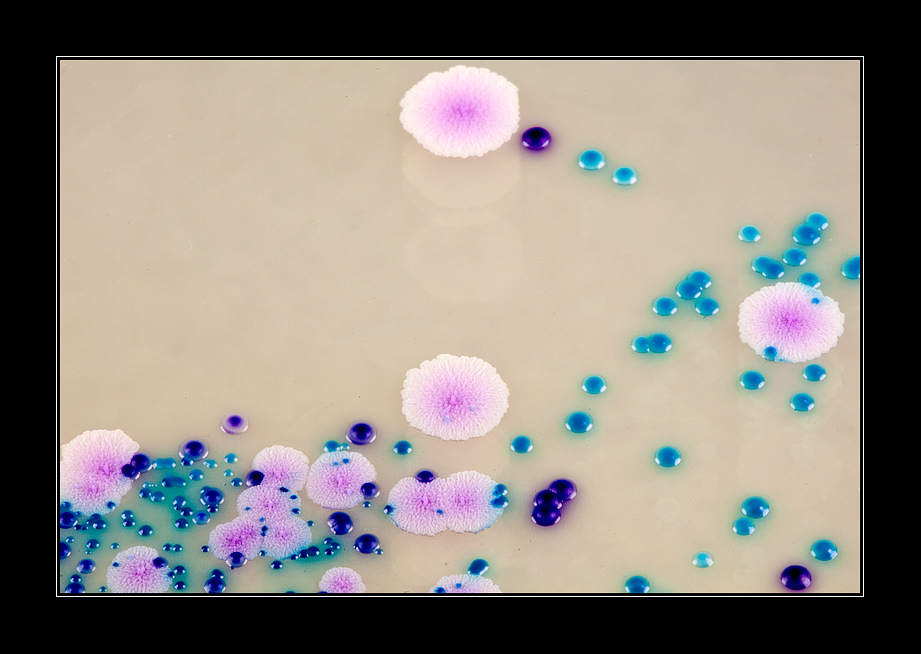
06.jpg
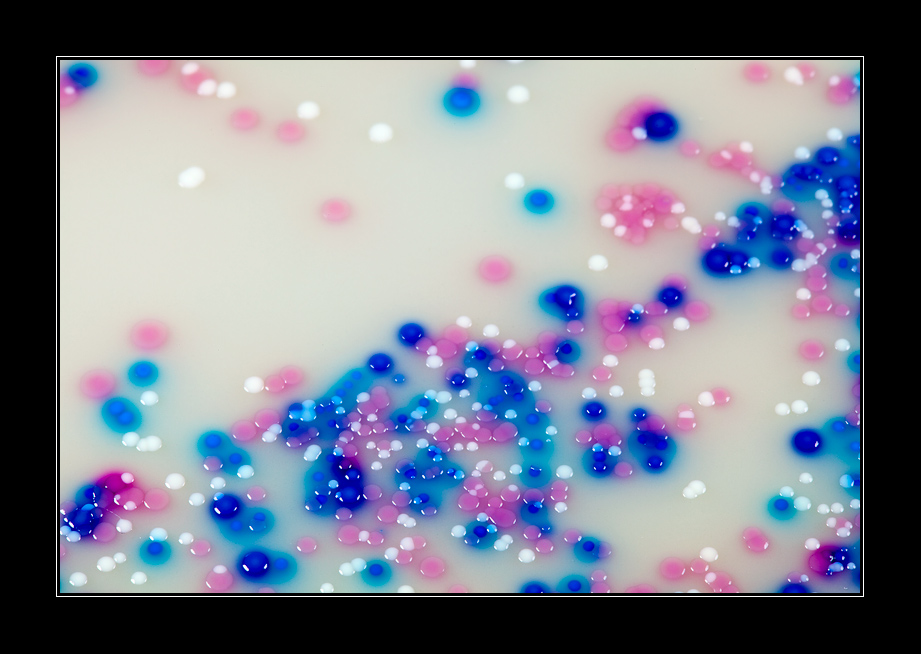
07.jpg
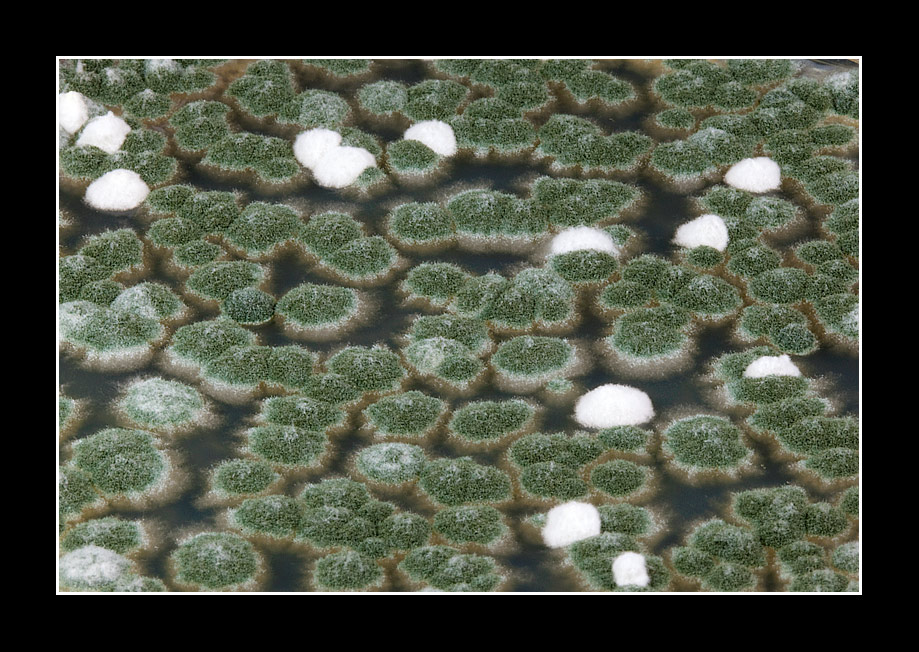
09.jpg

| Autore |
Messaggio |
cheroz utente attivo

Iscritto: 31 Mar 2007 Messaggi: 10794 Località: Provincia di Varese
|
Inviato: Mar 01 Giu, 2010 7:45 pm Oggetto: I colori dei microbi |
|
|
Suggerimenti e critiche sempre ben accetti.
Scatti di colonie microbiche sviluppate su dispositivi di circa 9 cm di diametro come quello della foto n° 11.
| Descrizione: |
|
| Dimensione: |
198.16 KB |
| Visualizzato: |
File visto o scaricato 2437 volta(e) |

|
| Descrizione: |
|
| Dimensione: |
195.89 KB |
| Visualizzato: |
File visto o scaricato 2436 volta(e) |
|
| Descrizione: |
|
| Dimensione: |
195.43 KB |
| Visualizzato: |
File visto o scaricato 2435 volta(e) |

|
| Descrizione: |
|
| Dimensione: |
194.47 KB |
| Visualizzato: |
File visto o scaricato 2433 volta(e) |

|
| Descrizione: |
|
| Dimensione: |
190.72 KB |
| Visualizzato: |
File visto o scaricato 2430 volta(e) |
|
| Descrizione: |
|
| Dimensione: |
195.4 KB |
| Visualizzato: |
File visto o scaricato 2428 volta(e) |
|
| Descrizione: |
|
| Dimensione: |
197.33 KB |
| Visualizzato: |
File visto o scaricato 2426 volta(e) |

|
| Descrizione: |
|
| Dimensione: |
194.68 KB |
| Visualizzato: |
File visto o scaricato 2425 volta(e) |
|
| Descrizione: |
|
| Dimensione: |
183.08 KB |
| Visualizzato: |
File visto o scaricato 2423 volta(e) |

|
| Descrizione: |
|
| Dimensione: |
197.75 KB |
| Visualizzato: |
File visto o scaricato 2422 volta(e) |

|
_________________ La mia intervista su photo4u °°° Tutorial “in the round” °°° Vedo i fiumi dentro le mie vene, cercano il loro mare, rompono gli argini, trovano cieli da fotografare (F. De André)°°° Cheroz è Fiorenzo Carozzi. |
|
Vai ad inizio pagina Vai a fine pagina |
|
 |
davIvad utente

Iscritto: 24 Giu 2009 Messaggi: 408 Località: Roma
|
Inviato: Mar 01 Giu, 2010 7:55 pm Oggetto: |
|
|
Bella questa serie di immagini al microscopio! Che ingrandimento è? I colori sono messi in post, ottenuti da coloranti o come?
2, 4, e 9 le mie preferite
.. sarebbe anche bello sapere di cosa si tratta
_________________ Canon EOS 40D * EF-S 10-22 * EF-S 18-55 IS * EF-S 55-250 IS + Nikon FG * Nikon 50mm 1.8 serie E * 28mm 2.8 serie E
The beauty of light, il mio fotoblog. Qui potete trovare le versioni ad alta risoluzione delle foto postate nel forum.
Flickr |
|
Vai ad inizio pagina Vai a fine pagina |
|
 |
cheroz utente attivo

Iscritto: 31 Mar 2007 Messaggi: 10794 Località: Provincia di Varese
|
Inviato: Mar 01 Giu, 2010 8:01 pm Oggetto: |
|
|
| davIvad ha scritto: | Bella questa serie di immagini al microscopio! Che ingrandimento è? I colori sono messi in post, ottenuti da coloranti o come?
2, 4, e 9 le mie preferite
.. sarebbe anche bello sapere di cosa si tratta  |
grazie davIvad.
sono macro realizzate con obiettivo 100 mm ad una distanza di circa 35 cm (circa 1:1); sono colonie di microbi (aggregati) coltivate su substrati di coltura specifici che o le colora o ne aumenta i pigmenti naturali o le rende fluorescenti (come nella n° 10). Non sono fatte al microscopio essendo le "colonie" degli aggregati di microbi di 2-10mm.
mi scuso per i dettagli tecnici ma è per una maggiore comprensione.
ciao
fiò
_________________ La mia intervista su photo4u °°° Tutorial “in the round” °°° Vedo i fiumi dentro le mie vene, cercano il loro mare, rompono gli argini, trovano cieli da fotografare (F. De André)°°° Cheroz è Fiorenzo Carozzi. |
|
Vai ad inizio pagina Vai a fine pagina |
|
 |
Sisto Perina bannato

Iscritto: 16 Giu 2007 Messaggi: 21882
|
Inviato: Mar 01 Giu, 2010 8:05 pm Oggetto: |
|
|
Sto commentando a distanza di sicurezza dal monitor....con tutti questi microbi in giro!!!
Virus, batteri, funghi e quant'altro (immagino ci sia di tutto di più.... ) che si presentano in multicolor sui nostri schermi...
Studio interessante che mi porta a rimembrare in alcuni scatti (foto 4, 6 e 7) le vecchie palline "zigulì" (se qualcuno le ricorda....beh magari esistono ancora...), in altri (foto d'apertura) le superfici degli stagni ricoperte di ninfee,per continuare (foto 9) con le zolle di muschio che uso per il presepe e (foto 2) la pianta di un piede tronca di ben 4 dita....
ah beh (foto 3) bellissime "uova al tegamino"....
scusa la diversa lettura
ciaoo
|
|
Vai ad inizio pagina Vai a fine pagina |
|
 |
onaizit8 utente attivo

Iscritto: 07 Ott 2007 Messaggi: 16276 Località: pistoia italia
|
Inviato: Mar 01 Giu, 2010 8:05 pm Oggetto: |
|
|
| Non sapevo che tu fossi un appassionato di questo genere di immagini. Sono davvero interessanti. Alcune stupefacenti, la 4, la 10 ma anche la 9. Mondi paralleli, micromondi. Paesaggi di un'altra dimensione e di astrazione, ma pur sempre paesaggi. Bravo. Ciao Tiziano
|
|
Vai ad inizio pagina Vai a fine pagina |
|
 |
davIvad utente

Iscritto: 24 Giu 2009 Messaggi: 408 Località: Roma
|
Inviato: Mar 01 Giu, 2010 8:34 pm Oggetto: |
|
|
| cheroz ha scritto: | grazie davIvad.
sono macro realizzate con obiettivo 100 mm ad una distanza di circa 35 cm (circa 1:1); sono colonie di microbi (aggregati) coltivate su substrati di coltura specifici che o le colora o ne aumenta i pigmenti naturali o le rende fluorescenti (come nella n° 10). Non sono fatte al microscopio essendo le "colonie" degli aggregati di microbi di 2-10mm.
mi scuso per i dettagli tecnici ma è per una maggiore comprensione.
ciao
fiò |
Grazie per la spiegazione, ero sicuro che si trattasse di tessuti, cellule o microorganismi quindi su scale molto più piccole.. affascinante, devo ammettere
_________________ Canon EOS 40D * EF-S 10-22 * EF-S 18-55 IS * EF-S 55-250 IS + Nikon FG * Nikon 50mm 1.8 serie E * 28mm 2.8 serie E
The beauty of light, il mio fotoblog. Qui potete trovare le versioni ad alta risoluzione delle foto postate nel forum.
Flickr |
|
Vai ad inizio pagina Vai a fine pagina |
|
 |
Clara Ravaglia utente attivo

Iscritto: 19 Feb 2006 Messaggi: 27260 Località: Ravenna
|
Inviato: Mar 01 Giu, 2010 9:11 pm Oggetto: |
|
|
Ma guarda un po'.. mi hai fatto tornare indietro di tanto tempo, al volontariato in laboratorio analisi, con tante piastre di Petri e colture in agar, da non finire più. Tutti si annoiavano, invece a me piaceva.
Nitidissime ed esaltate dalle tinte accattivanti.
Se sono in microbiologia ci si potesse fidare del fascino delle tinte.....
Idea fotografica originale, a dir poco.
Ciao
Clara
_________________ Clara Ravaglia |
|
Vai ad inizio pagina Vai a fine pagina |
|
 |
cheroz utente attivo

Iscritto: 31 Mar 2007 Messaggi: 10794 Località: Provincia di Varese
|
Inviato: Mar 01 Giu, 2010 9:55 pm Oggetto: |
|
|
grazie per i commenti.
@ sisto: divertente la tua lettura delle immagini che evocano anche a me più realistici scenari (impronte, coriandoli, uova, ecc)
@ tiziano: con questi microbi ci lavoro e con i mezzi tecnici che ora ho (arricchiti di recente con un 100mm macro) mi sono organizzato per fotografarli e mi è piaciuto un sacco, per i colori, le forme, mi sono dovuto ingegnare con supporti, luci e riflettere sull'angolatora corretta sui diaframma, la pdc, insomma su tutte le problematiche delle fotografie "normali"!!
@ clara: mi fa piacere averti fatto fare un tuffo nel passato, nella tua pratica di laboratorio; l'idea di questa serie mi è un po' venuta vedendo il reportage dal tuo studio
ciao, fiò
_________________ La mia intervista su photo4u °°° Tutorial “in the round” °°° Vedo i fiumi dentro le mie vene, cercano il loro mare, rompono gli argini, trovano cieli da fotografare (F. De André)°°° Cheroz è Fiorenzo Carozzi. |
|
Vai ad inizio pagina Vai a fine pagina |
|
 |
Francesco Ercolano utente attivo

Iscritto: 26 Giu 2008 Messaggi: 13427 Località: Piano di Sorrento (Na)
|
Inviato: Mar 01 Giu, 2010 10:05 pm Oggetto: |
|
|
Beh, stasera ci proponi un lavoro di grande fascino e interesse...
...interessante e anche divertente grazie alla bella lettura di Sisto...
Complimenti di cuore...hai unito la tua passione per la Fotografia a quella per il tuo lavoro regalandoci una straordinaria serie di immagini...
La mia preferita la 10...non avrebbe sfigurato in post singolo come "astratto", a mio parere naturalmente...
Bravissimo,
Franco
_________________ Dove Gli Alberi Piangono.. Impressionismi Sulle Orme di Giovannino... Pastelli Marinari
Life is like a chocolate box... |
|
Vai ad inizio pagina Vai a fine pagina |
|
 |
pentaxteo utente attivo

Iscritto: 27 Mgg 2008 Messaggi: 2309 Località: Salento
|
Inviato: Mar 01 Giu, 2010 10:19 pm Oggetto: |
|
|
A parte che con voi condivido la visione "altra" di questi microbi: ninfee, uova, coriandoli, il bruco, ecc ecc. Detto questo non posso che fare i complimenti al grande Cheroz che ha reso artistici questi scatti da laboratorio. Secondo me qualche amante/impiegato del settore potrebbe acquistarli tutti! Ma non solo, credo che siano ottime proposte d'arredo per ambienti più moderni e "in". Ovviamente prendilo come un grande complimento.
E per l'appunto... complimenti!
Matteo.
_________________ "[...] Felice chi, semplice, si libra sulla vita e intende il linguaggio dei fiori e delle cose mute."
Charles Baudelaire. |
|
Vai ad inizio pagina Vai a fine pagina |
|
 |
francodipisa utente attivo

Iscritto: 30 Ago 2007 Messaggi: 11116 Località: Pisa
|
Inviato: Mer 02 Giu, 2010 10:41 am Oggetto: |
|
|
Immagini tutte bellissime, con la firma di un paesaggista di talento che sa vedere la bellezza di paesaggi inconsueti e valorizzarla indipendentemente dalla scala di dimensioni. Un plauso per tutta la serie.
Ciao
_________________ Franco fotografato da Onaizit8 - Stando a Pisa posso farle anche pendere un po', ma mai un pò con l'accento ( ) o un po senza apostrofo ( )!
E' l'ordinario che voglio fotografare, prima che svanisca come il mondo della mia giovinezza... |
|
Vai ad inizio pagina Vai a fine pagina |
|
 |
NEROAVORIO utente attivo
Iscritto: 03 Feb 2008 Messaggi: 21688
|
Inviato: Mer 02 Giu, 2010 11:45 am Oggetto: |
|
|
| ...un lavoro ben fatto e affascinante... ci hai mostrato l'altra faccia di cose maligne, che hanno colori bellissimi, ciao
|
|
Vai ad inizio pagina Vai a fine pagina |
|
 |
acromion76 utente
Iscritto: 24 Mgg 2008 Messaggi: 60 Località: atlantide
|
Inviato: Mer 02 Giu, 2010 4:56 pm Oggetto: |
|
|
interessante settore.... dovresti fare una bella mostra di microbi e affini
_________________ www.shadowshallow.com
canon 5DII+Canon 350D+ BG + 24-70 f2.8 + 100-400 f4.5-5.6 + sigma 12-24 + sigma 180 Macro! |
|
Vai ad inizio pagina Vai a fine pagina |
|
 |
cheroz utente attivo

Iscritto: 31 Mar 2007 Messaggi: 10794 Località: Provincia di Varese
|
Inviato: Mer 02 Giu, 2010 7:42 pm Oggetto: |
|
|
ringrazio di cuore gli amici che hanno lasciato un'impressione ed un pensiero su questi scatti: francesco, matteo, franco(dipisa), franco(neroavorio), acromion76.
@francodipisa: mi è piaciuta l'immagine del micro-paesaggista...
@matteo: proverò a metterne qualcuna su fotolia...non si sa mai...
@neroavorio: in effetti alcuni di questi sono proprio maligni, ma alla fine ho sterilizzato anche negli anfratti la mia preziosa 5DII
ciao
fiò
_________________ La mia intervista su photo4u °°° Tutorial “in the round” °°° Vedo i fiumi dentro le mie vene, cercano il loro mare, rompono gli argini, trovano cieli da fotografare (F. De André)°°° Cheroz è Fiorenzo Carozzi. |
|
Vai ad inizio pagina Vai a fine pagina |
|
 |
Massimo Passalacqua utente attivo

Iscritto: 04 Dic 2005 Messaggi: 18511 Località: Siena
|
Inviato: Mer 02 Giu, 2010 8:33 pm Oggetto: |
|
|
Forme, colori, textures estremamente gradevoli e interessanti.
Una bella serie!
Ciao.
massimo
_________________ massimo (già sanpit) |
|
Vai ad inizio pagina Vai a fine pagina |
|
 |
marco64 utente attivo

Iscritto: 09 Lug 2007 Messaggi: 12875 Località: Milano
|
Inviato: Gio 03 Giu, 2010 8:37 pm Oggetto: |
|
|
Ben fatto; la terza e quella che preferisco.
Ciao
_________________ Libertà l'ho vista dormire nei campi coltivati a cielo e denaro, a cielo ed amore, protetta da un filo spinato.
La mia galleria su Streephers |
|
Vai ad inizio pagina Vai a fine pagina |
|
 |
freeadam utente attivo

Iscritto: 18 Feb 2008 Messaggi: 10121 Località: Terracina (LT)
|
Inviato: Ven 04 Giu, 2010 7:21 pm Oggetto: |
|
|
Riesci a scovare la bellezza ovunque e a mostrarcela sempre con la tua solita bravura.
Grande Fiò!!!
_________________ Francesco
→ → → → → → → il mio ultimo post
Nikon D7000 - Nikon D40X - Nikkor AF-S DX 10-24mm f/3.5-4.5 G ED - Nikkor AF-S DX 18-200 mm f/3.5-5.6 G II ED - polarizzatore circolare Hoya - filtro digradante grigio 502 B+W - filtro grigio ND8 Hoya - filtro grigio ND400 Hoya |
|
Vai ad inizio pagina Vai a fine pagina |
|
 |
cheroz utente attivo

Iscritto: 31 Mar 2007 Messaggi: 10794 Località: Provincia di Varese
|
Inviato: Ven 04 Giu, 2010 8:28 pm Oggetto: |
|
|
GRAZIE a massimo, marco, francesco .....e....consentitemi questo piccolo divertissement, (qui sotto), in onore di photo4U, sempre con i colori dei microbi....
ciao, fiò
| Descrizione: |
|
| Dimensione: |
195.32 KB |
| Visualizzato: |
File visto o scaricato 2173 volta(e) |

|
_________________ La mia intervista su photo4u °°° Tutorial “in the round” °°° Vedo i fiumi dentro le mie vene, cercano il loro mare, rompono gli argini, trovano cieli da fotografare (F. De André)°°° Cheroz è Fiorenzo Carozzi. |
|
Vai ad inizio pagina Vai a fine pagina |
|
 |
roby 2 utente attivo
Iscritto: 10 Set 2008 Messaggi: 9516
|
Inviato: Mer 09 Giu, 2010 8:10 am Oggetto: |
|
|
| Originali e ben fatte, un pò fuori dal tuo consueto. CIAO.
|
|
Vai ad inizio pagina Vai a fine pagina |
|
 |
gred utente attivo

Iscritto: 16 Feb 2007 Messaggi: 780 Località: umbria
|
Inviato: Gio 17 Giu, 2010 12:36 pm Oggetto: |
|
|
Un bellissimo astratto naturale con colori delicati e piacevolissimi, complimenti
ciao
Daniela
_________________ in questo momento mi vergogno di essere italiana... |
|
Vai ad inizio pagina Vai a fine pagina |
|
 |
|